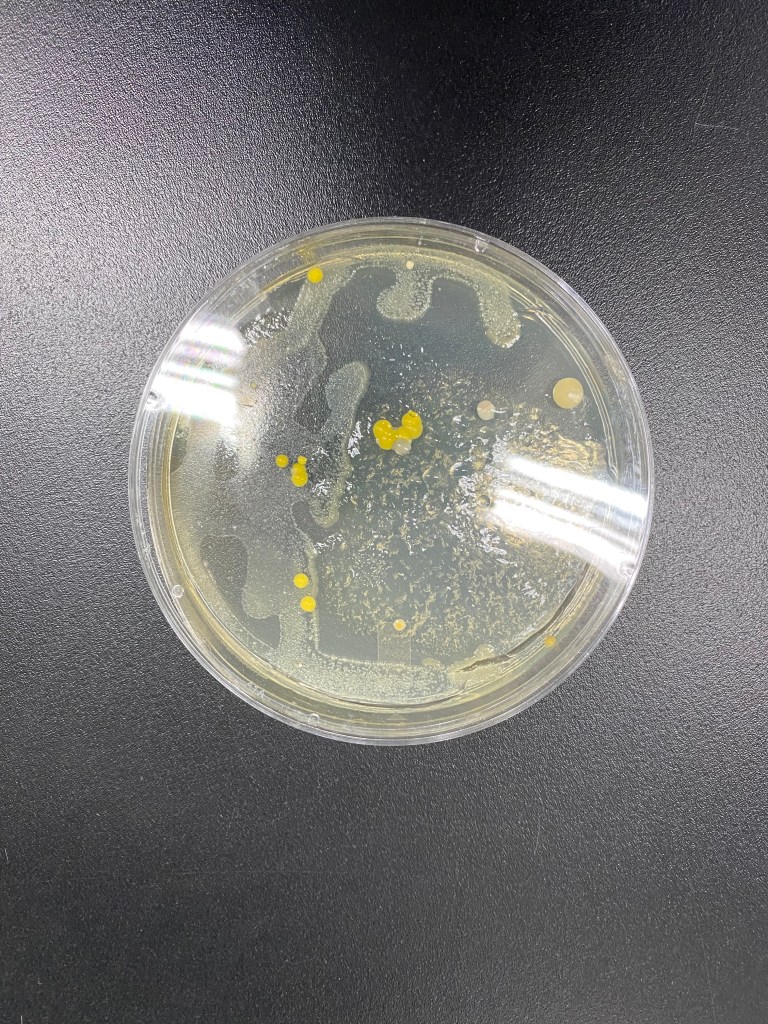
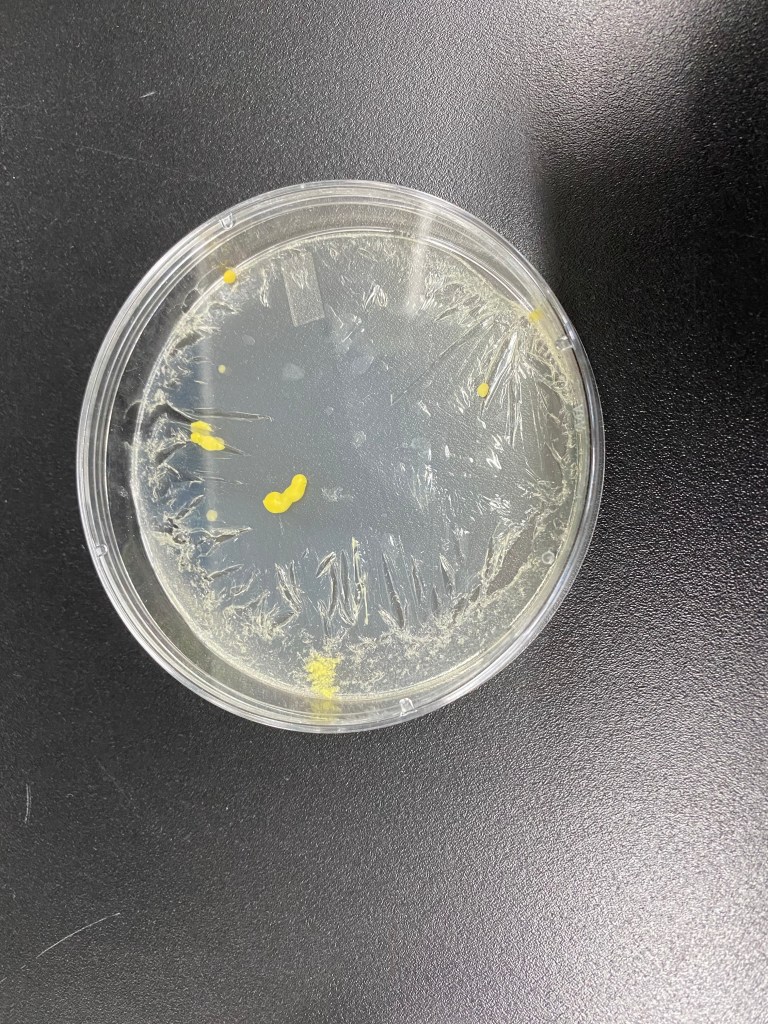
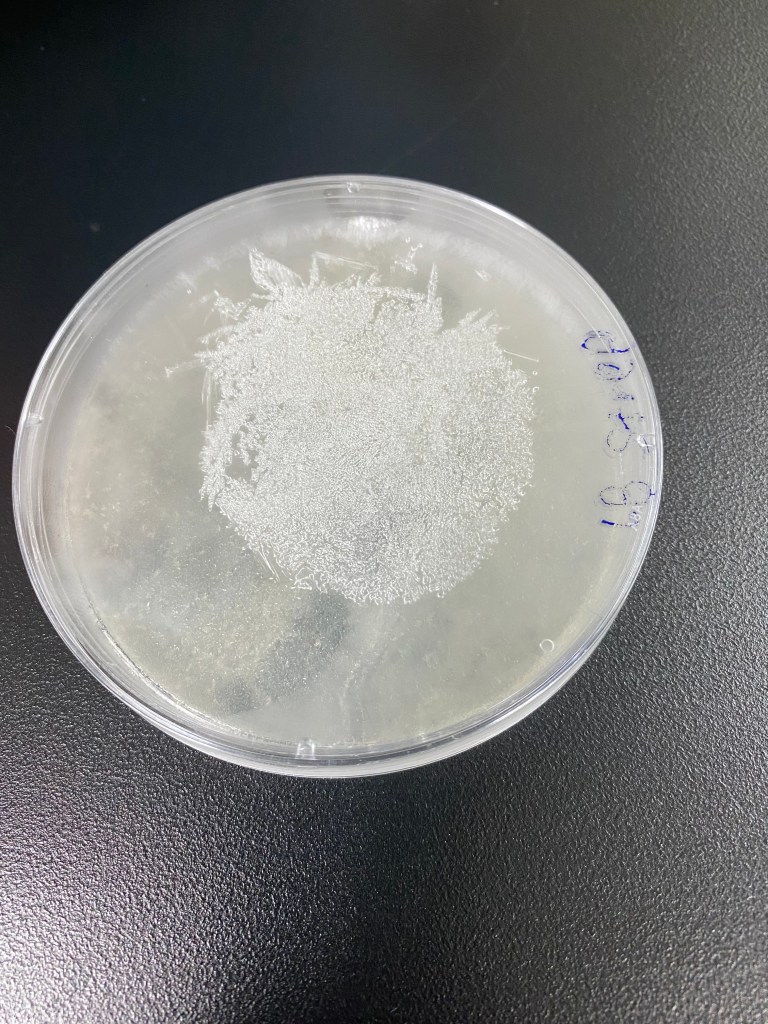
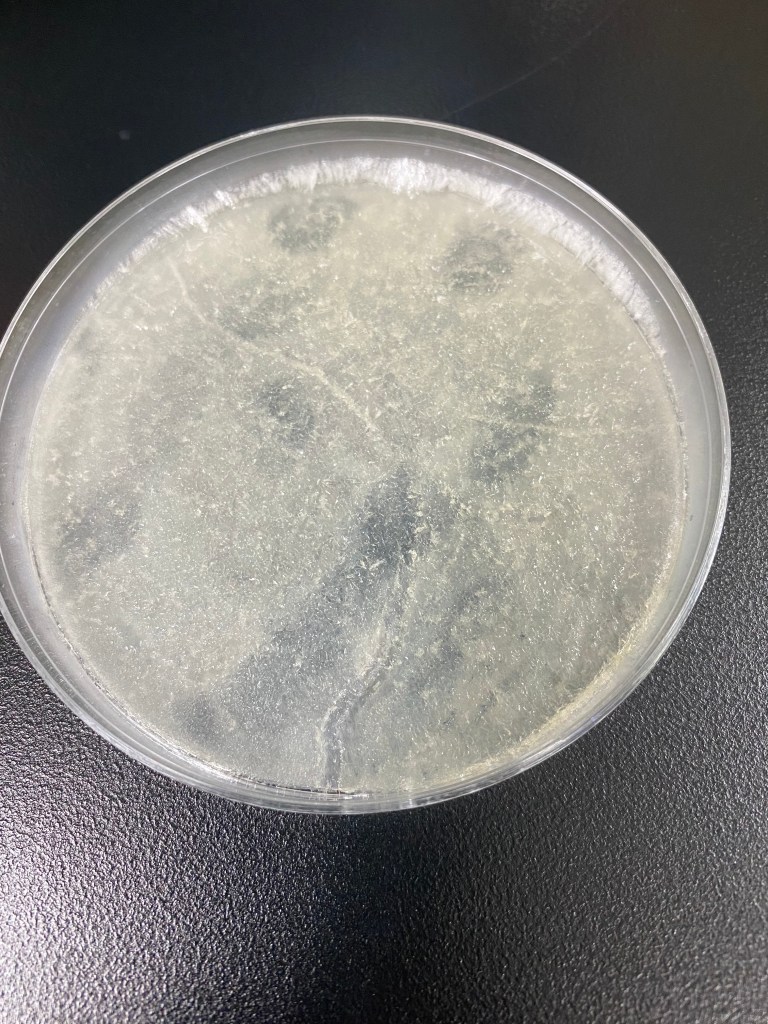
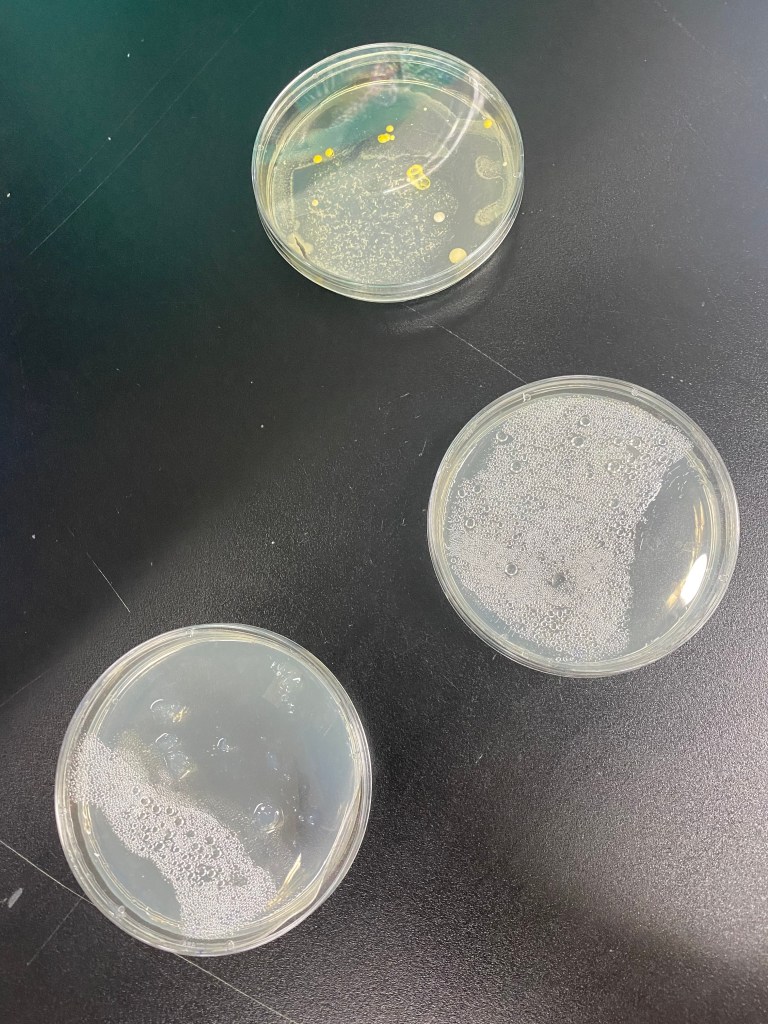
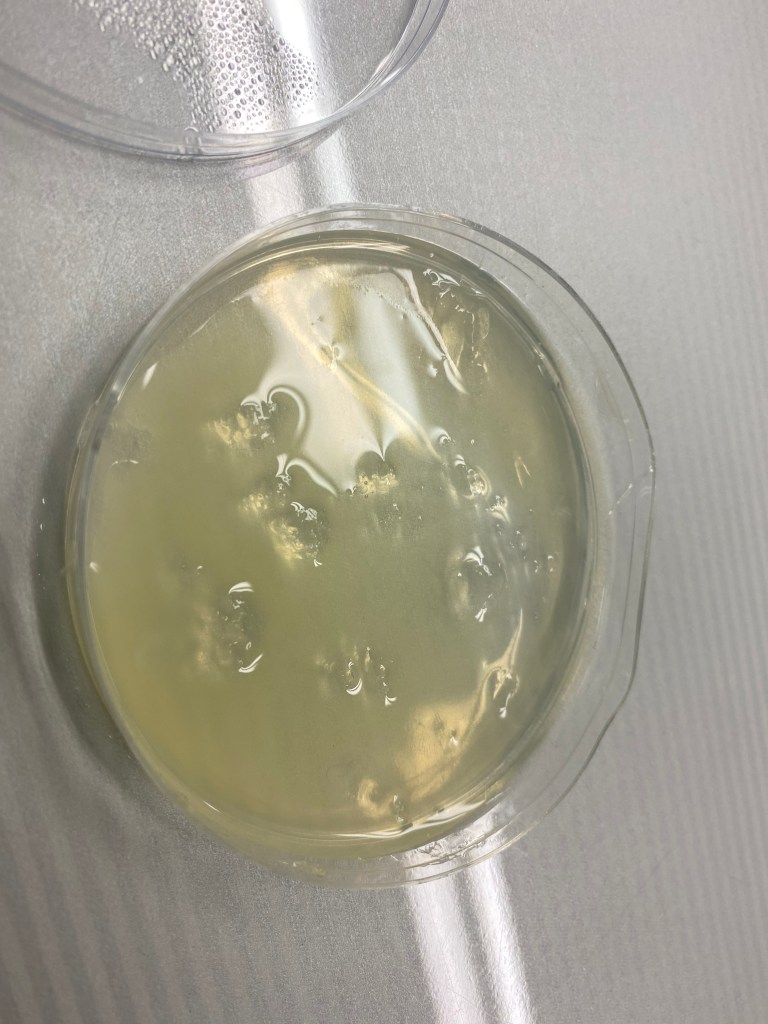
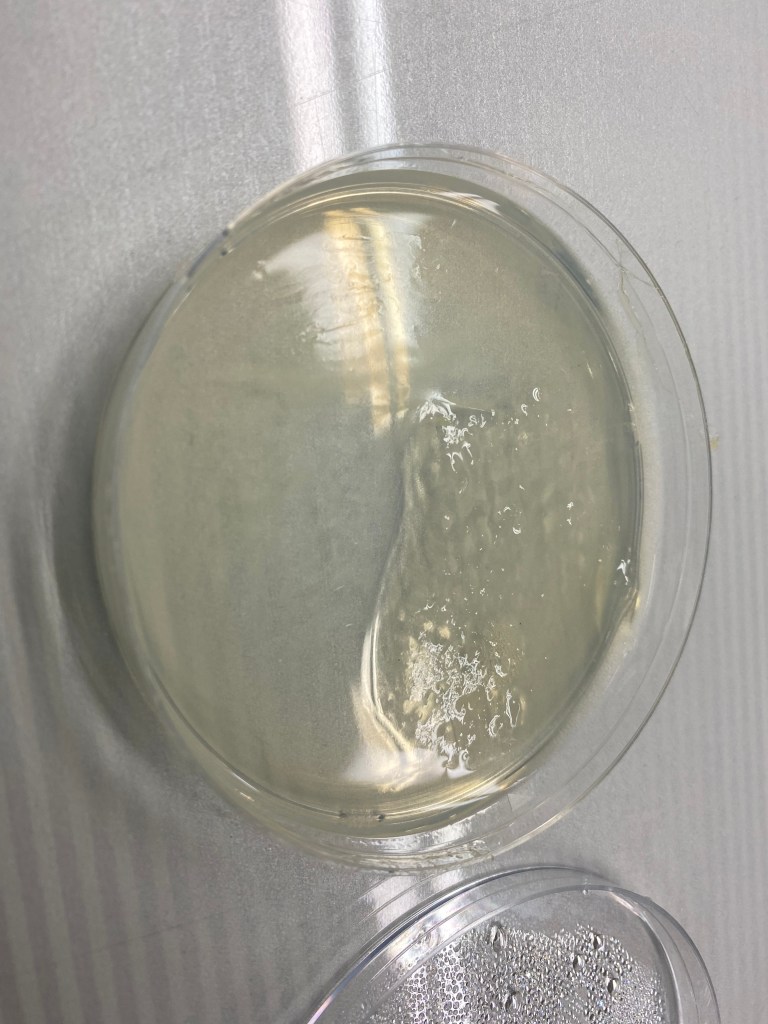

Before moving onto my processes today, I must address a major failure that may affect our results.. We had to re-microwave the frozen agar plates, which led to contamination on some of the plates. We actually only re-microwaved one plate and left the other plate alone. This resulted in one of the Agar plates being contaminated with possibly streptococcus bacteria, which is the white specks.

However, contrary to my summer experiment of ’20, this was the first time my E.Coli bacteria was very beady and bright yellow. I searched up “E.Coli colonies on LB Agar” to check if the bacteria I was growing was the correct one, because my colonies weren’t congruent to the ones I had cultivated last summer AND the pictures I found on the internet. But, my biology teacher assured me that it was probably because the company may have altered the genes of the E.Coli bacteria to be more colorful to be more evident in data collection. Honestly? I’m not so sure..
We also took out our LB Strep agar plates, which were ALSO frozen.

So, while I was creating the Bacterial Transformation Mix, my biology teacher re-microwaved the plates again. But I’m very concerned about the process because the I realized he melted the Agar plates with the plates itself, so if the plastic melted into the LB Agar solutions, then what could possibly happen? Maybe that was why the transformed bacteria didn’t fully cultivate?
Now, time to create the Bacterial Transformation Mix~!

I first violently stabbed the pipette onto the pipette tips, following my biology teacher’s advice. I pipetted 100µL of the bacterial transformation mix into a new centrifuge tube.

Then, I inoculated some bacteria off of the re-microwaved plate because it was a bit more cleaner than the dried up LB Agar plate. However, like last time, the bacteria wouldn’t fall off the inoculation loop while mixing, so we tried various methods of trying to dissolve it – flicking it, holding the tube in hot water while mixing, vigorously mixing it, scraping it off with another smaller inoculation loop.
After the bacteria had finally fallen off the loop, the bacteria wouldn’t mix. So, my biology teacher suggested to pipette the solution multiple times to make sure the bacteria fully mixed with the transformation mix solution.

We added 10µL of the Cas9 solution to the competent cell mixture using the pipette, then added 10µL of the gRNA solution to the same competent cell mixture that we added the Cas9 to. We also added 10µL of the Template DNA solution to the same competent cell mixture tat we added the Cas9 and gRNA solution to.
Then, we incubated this centrifuge into a refrigerator for 30 minutes. While incubating, we discussed and debated about various topics, which all were very interesting conversation topics.
After incubating the tube in the refrigerator, we immediately heat shocked the centrifuge in 42˚C of water.

Then, we added 1.5mL of water into one of the LB Agar centrifuges, and when the powder wouldn’t mix, I flicked the tube again, just like I learned.

We added the 1.5mL of LB Agar mixture into the bacterial transformation mix. Here is a photo of the new solution:

These are the two newly re-microwaved LB Strep plates:
This time, we decided to employ a control and experimental group to compare whether the CRISPR was really successful in transforming the bacteria to survive against the Streptomycin antibiotic.

The control group would be re-inoculating the cultivated E.Coli bacteria onto the LB Strep, and the experimental group would be the newly transformed E.Coli bacteria using Cas9 onto the LB Strep plates.

Finally, we waited in anticipation for the newly transformed bacteria colonies to appear!!
– Joanna Kim, May 16th, 2021, 5:17 PM